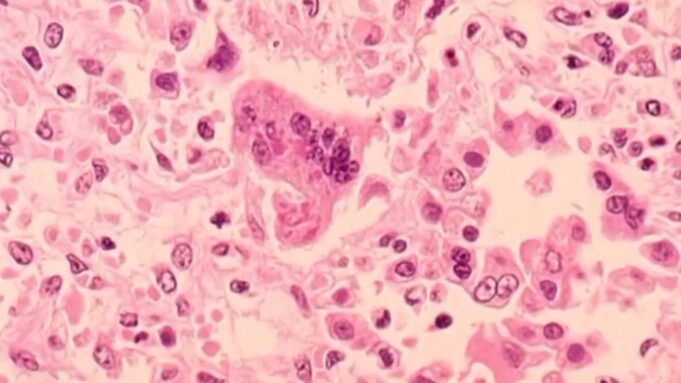

RALEIGH, Carolina del Nord — Un nuovo caso di morbillo è stato segnalato nella contea di Rutherford, nella Carolina del Nord, portando a cinque il numero totale di casi registrati nello stato dalla fine di dicembre, secondo il Dipartimento della salute e dei servizi umani della Carolina del Nord (NCDHHS).
Coloro che sono stati esposti sono stati informati.
Questi casi sono collegati all’epidemia in corso nella contea di Spartanburg, nella Carolina del Sud, dove funzionari statali hanno confermato 99 nuovi casi negli ultimi tre giorni, portando il totale a 310.
L’epidemia si è diffusa anche in Ohio tra le famiglie che viaggiavano nella zona.
I funzionari sanitari attribuiscono l’aumento ai viaggi di vacanza, alle riunioni di famiglia, ai bassi tassi di vaccinazione e alla maggiore esposizione del pubblico. Fino a venerdì, 200 persone erano in quarantena e nove persone erano in isolamento.
Dr., che sta guidando la risposta alle epidemie del dipartimento sanitario statale. “Il numero di persone messe in quarantena non riflette il numero di persone effettivamente esposte”, ha detto Linda Bell. “Si sta identificando un numero crescente di siti pubblici di esposizione dove forse sono state esposte altre centinaia di persone che non erano consapevoli di dover mettere in quarantena se non erano immuni al morbillo”.
Da ottobre il virus si è diffuso inosservato nella regione e centinaia di scolari sono stati messi in quarantena, alcuni ripetutamente. La Carolina del Sud è uno dei due focolai attivi del morbillo negli Stati Uniti; L’altro è il confine tra Arizona e Utah, dove da agosto si sono verificati 337 casi.
L’anno scorso si è verificata la peggiore epidemia di morbillo negli Stati Uniti dal 1991, con 2.144 casi in 44 stati. Gli esperti sanitari avvertono che il virus si sta avvicinando a un ritorno, mettendo potenzialmente fine allo status degli Stati Uniti di eliminare la diffusione locale, come è successo in Canada a novembre.
La stessa tensione si sta diffondendo nelle Americhe; Le preoccupazioni aumentano con l’avvicinarsi del primo anniversario della massiccia epidemia, che ha fatto ammalare 900 persone e ne ha uccise tre in Texas, New Mexico e Oklahoma.
Cos’è il morbillo?
Il morbillo è una malattia respiratoria che si diffonde nell’aria attraverso la tosse e gli starnuti. Può anche essere trasmesso attraverso il contatto con le secrezioni nasali o orali di una persona infetta. Il virus può sopravvivere nell’aria in cui è presente una persona infetta fino a due ore.
I sintomi di solito iniziano una o due settimane dopo l’esposizione, ma possono comparire fino a 21 giorni. Ciò include:
- Febbre alta (può superare i 104 gradi)
- Tosse
- rinorrea
- Occhi rossi e lacrimosi (congiuntivite)
- Piccole macchie bianche (macchie di Koplik) all’interno delle guance, delle gengive e del palato due o tre giorni dopo la comparsa dei sintomi
- Un’eruzione cutanea rossa, in rilievo e a chiazze; Di solito inizia sul viso e si diffonde al tronco, alle braccia e alle gambe da tre a cinque giorni dopo la comparsa dei sintomi.
Sebbene il programma di vaccinazione abbia ridotto significativamente i casi di morbillo negli Stati Uniti, secondo l’Organizzazione Mondiale della Sanità il morbillo è ancora una delle principali cause di morte tra i bambini a livello internazionale.
La malattia può portare a gravi complicazioni come polmonite ed encefalite, soprattutto nei bambini piccoli. Il morbillo ha ucciso 95.000 persone in tutto il mondo nel 2024; la maggior parte di questi erano bambini non vaccinati di età pari o inferiore a cinque anni.
VEDI ANCHE | L’NCDHHS evidenzia i vaccini nel contesto delle modifiche del CDC al programma di vaccinazione infantile
I funzionari della sanità pubblica raccomandano che tutte le persone non vaccinate di età pari o superiore a un anno ricevano il vaccino contro il morbillo. Il vaccino è raccomandato anche per i bambini di età compresa tra 6 e 11 mesi che viaggiano a livello internazionale o in aree in cui sono attive epidemie di morbillo.
L’Associated Press ha contribuito a questo rapporto.